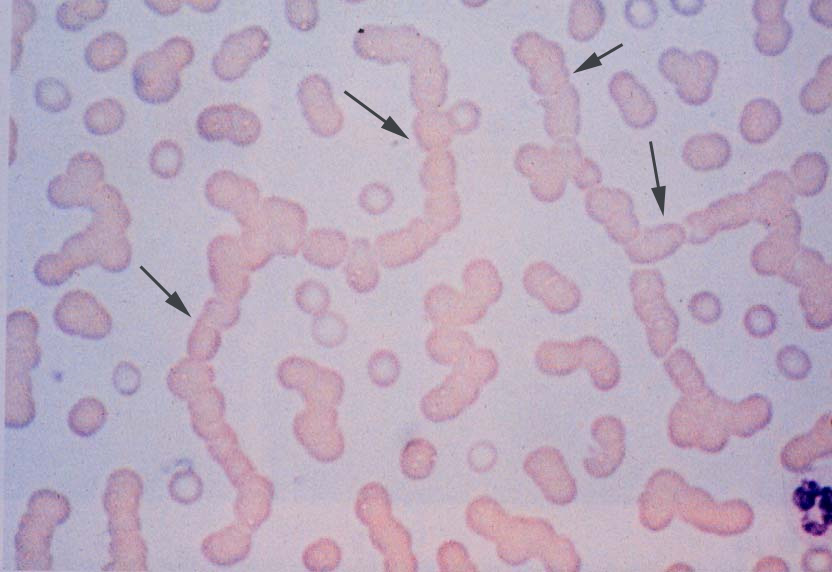
perifert blodudstryg med pengerulledannelse af erytrocytter jpg

Perifert blodudstryg med pengerulledannelse af erytrocytter
Perifert blodudstryg med pengerulledannelse (Rouleaux-fænomen) af erytrocytter hos en patient med myelomatose. Dette er betinget af højt proteinindhold i blodet.
Indhold leveret af
Patienthåndbogen
laegehaandbogen@dadl.dk
Patienthåndbogen
Kristianiagade 12
2100 København Ø
Disclaimer: Patienthåndbogen